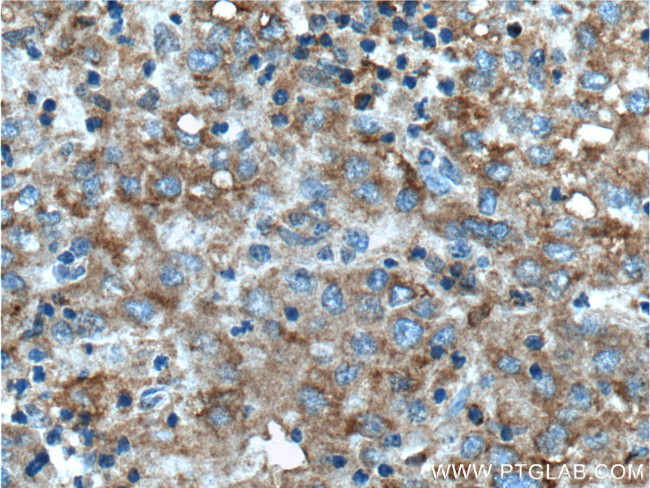
TIP30 Antibody in Immunohistochemistry (Paraffin) (IHC (P))

Search
Proteintech
TIP30 Polyclonal Antibody
{{$productOrderCtrl.translations['antibody.pdp.commerceCard.promotion.promotions']}}
{{$productOrderCtrl.translations['antibody.pdp.commerceCard.promotion.viewpromo']}}
{{$productOrderCtrl.translations['antibody.pdp.commerceCard.promotion.promocode']}}: {{promo.promoCode}} {{promo.promoTitle}} {{promo.promoDescription}}. {{$productOrderCtrl.translations['antibody.pdp.commerceCard.promotion.learnmore']}}
产品信息
10251-1-AP
种属反应
宿主/亚型
分类
类型
抗原
偶联物
形式
浓度
规格
纯化类型
保存液
内含物
保存条件
运输条件
产品详细信息
Immunogen sequence: DFRMQNKSV FILGASGETG RVLLKEILEQ GLFSKVTLIG RRKLTFDEEA YKNVNQEVVD FEKLDDYASA FQGHDVGFCC LGTTRGKAGA EGFVRVDRDY VLKSAELAKA GGCKHFNLLS SKGADKSSNF LYLQVKGEVE AKVEELKFDR YSVFRPGVLL CDRQESRPGE WLVRKFFGSL PDSWARGHSV PVVTVV (47-241 aa encoded by BC002439)
靶标信息
CC3 (HTATIP2) is a member of the short-chain dehydrogenases/reductases (SDR) family. It is a novel serine/threonine kinase that phosphorylates the C-terminal domain (CTD) of the largest RNA polymerase II subunit and induces the expression of apoptosis related genes Bad and Siva, as well as metastasis suppressor NM23-H2. It also interacts with an estrogen receptor alpha-interacting coactivator CIA and regulates ERalpha-mediated c-myc transcription.
仅用于科研。不用于诊断过程。未经明确授权不得转售。
生物信息学
蛋白别名: 30 kDa HIV-1 TAT-interacting protein; FLJ26963; HIV-1 tat interactive protein 2, 30 kDa homolog; HIV-1 Tat interactive protein 2, 30kDa; HIV-1 tat interactive protein 2, homolog; HIV-1 TAT-interactive protein 2; HTATIP2; oxidoreductase HTATIP2; Protein HTATIP2; short chain dehydrogenase/reductase family 44U, member 1; Tat-interacting protein (30kD); tat-interacting protein 30 kDa; unnamed protein product
基因别名: AW111545; CC3; HTATIP2; SDR44U1; TIP30
UniProt ID: (Human) Q9BUP3, (Mouse) Q9Z2G9, (Rat) B0BNF8
Entrez Gene ID: (Human) 10553, (Mouse) 53415, (Rat) 292935